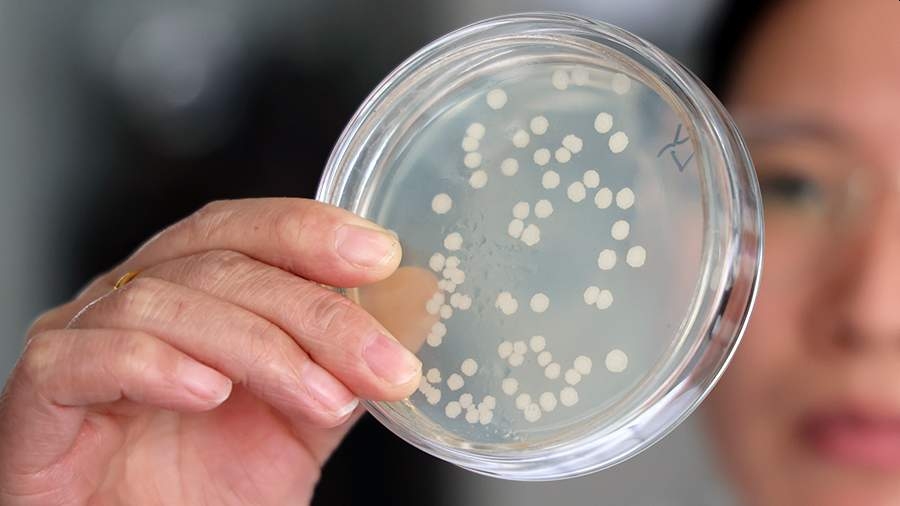
Биологи усомнились в неизбежной победе бактерий в гонке вооружений с антибиотиками

Крупный спонсор Партии реформ в Великобритании продал запчасти для оружия российскому поставщику. Об этом сообщает The New York Times.
Опубликовано 10:11, марта 29, 2025 в: «Политика»; Источник: eadaily.com; Поделиться:





В России выросли цены на запчасти для иномарок
В декабре 2024 года автозапчасти для иномарок подорожали на 10–12%. По итогам года 63% водителей жаловались на рост цен на запчасти. Их подорожание с …
15:11, февраля 25, 2025 | versia.ru
Британской Unilever разрешили продать бизнес в России
Британский производитель товаров повседневного спроса Unilever получил разрешение правительственной подкомиссии по иностранным инвестициям на продажу …
20:11, сентября 4, 2024 | gazeta.ru
И Shell с ней // С британской корпорации хотят взыскать миллиарды за ущерб, нанесенный России
В арбитражный суд Москвы подан иск Генпрокуратуры России, которая рассчитывает взыскать ущерб с корпорации Shell, нанесенный в связи с ее деятельност …
05:11, октября 5, 2024 | kommersant.ru
Иран, власть, общество: на пути реформ или конфронтации?
В начале наступившего тысячелетия Иран сталкивается с рядом внутри- и внешнеполитических вызовов, на которые ему пока не удается дать эффективные отв …
15:11, октября 26, 2025 | topwar.ru
«Программа реформ потребует большого количества электроэнергии»
Директор «Узатома» рассказал о перспективах сотрудничества Москвы и Ташкента в области атомной энергетики …
00:11, ноября 21, 2024 | vedomosti.ru
Спонсор подготовил речь об отставке для Байдена
Крупный спонсор демократической партии США составил черновик речи для американского президента Джо Байдена, в ходе которой он мог бы сообщить о том, …
15:11, июля 18, 2024 | gazeta.ru
Посол РФ назвал невозможной передачу Грецией вооружений ВСУ без согласия России
Греция не имеет права передавать российские вооружения Украине без письменного согласия российской стороны. Об этом заявил посол России в Греции Андр …
15:11, декабря 31, 2024 | news.rambler.ru
В США усмотрели риск новой гонки вооружений в решении России по РСМД
Решение Российской Федерации об отмене моратория на развёртывание ракет средней и меньшей дальности (РСМД) может привести к запуску новой гонки воору …
15:11, августа 5, 2025 | versia.ru
Стало известно имя главного «архитектора» реформ в команде Трампа
Назначенный в феврале главой Административно-бюджетного управления Белого дома Рассел Воут превратился в одну из самых влиятельных фигур в Вашингтоне …
00:11, апреля 22, 2025 | versia.ru
«Миротворец» Трамп – главный спонсор оборонных компаний США
Противники России полны парадоксов. В Америке к власти пришел президент, всерьез претендующий на Нобелевскую премию мира. Только вот акции оборонных …
05:11, ноября 9, 2025 | topwar.ru
"Спонсор" праздника на рынке на этой неделе - "Газпром"
Российский рынок завершил текущую торговую неделю позитивно, хотя в какой-то момент казалось, что ситуация катастрофичная. До заседания ЦБ по ставке …
20:11, июля 20, 2024 | finam.ru
Гонка ИИ-вооружений: Anthropic закрывает доступ к своим моделям для России и Китая
Американская компания Anthropic, разработчик языковой модели Claude, ужесточила свои условия обслуживания, запретив компаниям, контролируемым большин …
10:11, сентября 6, 2025 | ixbt.com
Путин: в ВС России должны поступить серийные типы БПЛА и других вооружений
Президент Владимир Путин сказал, что в России реализуется программа комплексного переоснащения армии и флота. В рамках этой программы на вооружение В …
15:11, сентября 19, 2024 | kommersant.ru
Реквием по конвенции, «матрица реформ» и новый Мальбрук: утренний кофе с EADaily
Мне кажется, что забрезжил свет в конце туннеля. Во-первых, ответ России немного привел в чувство западных политиков. Кроме, конечно, парочки полнейш …
10:11, ноября 23, 2024 | eadaily.com
Депутат «продавал» участникам СВО награды и отпуска
Суд в Брянской области вынес приговор бывшему депутату Клинцовского горсовета Владимиру Реуку, обвинённому в мошенничестве с выплатами участникам спе …
00:11, июля 29, 2025 | versia.ru
Усеченный вдвое пакет шоковых реформ Милея спустя полгода прошел сенат
Но ему вновь надо пройти нижнюю палату, а эксперты прогнозируют падение экономики Аргентины в 2024 году …
01:32, июня 14, 2024 | vedomosti.ru
Криптовалютный гигант в Дубае: Bybit демонстрирует лидерство на TOKEN2049 как золотой спонсор
Bybit – вторая по торговому объему криптовалютная биржа в мире... Сообщение Криптовалютный гигант в Дубае: Bybit демонстрирует лидерство на TOK …
10:11, апреля 30, 2025 | gadgets.su
Продавал спокойствие за 10 тысяч: полицейский погорел на взятках
Московский суд принял решение о заключении под стражу сотрудника патрульно-постовой службы Дмитрия Жукова, которого обвиняют в шести случаях корыстны …
10:11, октября 29, 2025 | pravda.ru
Чем известен зампред партии «Яблоко» Максим Круглов // Зампреда партии «Яблоко» Максима Круглова задержали по делу о фейках об армии
1 октября в Санкт-Петербурге задержали зампреда партии «Яблоко» Максима Круглова. Его подозревают в распространении фейков о ВС РФ. Подробности карье …
20:11, октября 1, 2025 | kommersant.ru
Прописка за деньги: житель Камчатки продавал воздух иностранцам
В Петропавловске-Камчатском 35-летний безработный местный житель устроил поддельную миграционную регистрацию для 31 человека из других стран по адрес …
10:11, октября 29, 2025 | pravda.ru
Житель Череповца продавал мошенникам персональные данные россиян
В Череповце задержан руководитель колл-центра, обслуживавшего МФЦ и медицинские учреждения, который продал мошенникам персональные данные более 27 ты …
15:11, июля 25, 2025 | versia.ru
Сервис хранения фотографий продавал сканы лиц сторонним компаниям
Photobucket столкнулась с коллективным иском после того, как стало известно, что она продавала фотографии пользователей, включая биометрические данны …
20:11, декабря 13, 2024 | ferra.ru
Спонсор летней грусти: как Лана Дель Рей стала одной из самых влиятельных певиц мира
Творчество Ланы Дель Рей отличается от того, что принято называть поп-музыкой. Нежные баллады, навевающие мысли о 1950-х, стали зеркалом Америки. Тре …
15:11, июня 21, 2025 | forbes.ru
Times: Эпштейн продавал секреты принца Эндрю иностранным спецслужбам
В новой книге историка Эндрю Лоуни «Право имеющий: взлёт и падение дома Йорков» содержатся шокирующие разоблачения о связях покойного американского ф …
20:11, августа 4, 2025 | versia.ru
Times: Эпштейн продавал тайны извращенца принца Эндрю «Моссаду» Скандально известный американский финансист Джеффри Эпштейн, найденный повешенным в тюрьме, был знаком с британским принцем Эндрю и продавал его инти …
20:11, августа 4, 2025 | eadaily.com
Есть ли перспективы у демократической партии в России По оценкам отдельных экспертов и политиков, численность отечественного «демократического электората» может составлять до трети всех избирателей стран …
00:11, декабря 23, 2025 | versia.ru
Спонсор своих проблем // Рэпера Гуфа судят за хищение iPhone в ходе потасовки в банном комплексе В Подмосковье суд приступил к рассмотрению уголовного дела рэпера Алексея Долматова (Гуф). Ему инкриминируют грабеж с применением насилия. По версии …
20:11, января 14, 2026 | kommersant.ru
Сын арестованного зама Шойгу — Попов продавал военную форму в интернете — Shot Сын задержанного сегодня по обвинению в мошенничестве экс-замминистра обороны РФ генерала армии Пала Попова Роман два года торговал в интернете военн …
20:11, августа 29, 2024 | eadaily.com
В России продают классическую «Ниву» из первой партии — ей 48 лет В Новосибирске продают самую первую «Ниву» — машину 1977 года из первой партии (автомобиль собран летом — при том, что « …
05:11, марта 10, 2025 | ixbt.com
Провели как обычно // Парламентские партии встретили День России Акции к Дню России организовали «Единая Россия» (ЕР), ЛДПР и «Справедливая Россия — За правду» (СРЗП). В своих поздравлениях их лидеры акцентировали …
01:48, июня 13, 2024 | kommersant.ru
Ветеран СВО вышел из «Справедливой России» из-за конфликта с руководством партии Руководитель саратовского отделения «Справедливой России», депутат местной облдумы и ветеран СВО Артем Чеботарев вышел из партии. Политик сообщил «Ъ» …
05:11, января 18, 2026 | kommersant.ru
С начала года в России выявили крупные партии чая с пестицидами С начала 2025 года в России было изъято из оборота свыше 111 тонн чая, в составе которого специалисты обнаружили пестициды. Нарушения были установлен …
10:11, октября 2, 2025 | versia.ru
«Нестле» отозвала в России некоторые партии детского питания из-за цереулида «Нестле Россия» отозвала ограниченное количество партий детского питания. Причиной в компании назвали усиление контроля качества сырья. …
20:11, января 6, 2026 | kommersant.ru
В Нефтеюганске члена «Единой России» исключили из партии за оскорбление уборщицы В Нефтеюганске (Ханты-Мансийский автономный округ, ХМАО—Югра) члена «Единой России» Альберта Афлятунова исключили из партии за хамское поведение, соо …
00:11, мая 22, 2025 | kommersant.ru
Депутатов «Единой России» попросили участвовать в мероприятиях кандидатов партии Также во время региональной недели они должны вести разъяснительную работу по налоговым изменениям и другим социальным вопросам …
05:11, июля 15, 2024 | vedomosti.ru
Глава СВР России указал, что скрывает глобальная «партии войны» в Европе Действующая в Европе глобальная «партия войны» не хочет установления прочного и справедливого мира на континенте, чтобы скрыть бесполезность вложений …
10:11, октября 17, 2025 | eadaily.com
iOS 18 сможет блокировать ворованные запчасти Вместе с выходом iOS 18, который станет доступна 16 сентября, Apple запустит сервис Блокировки активации, или Activation Lock. …
20:11, сентября 13, 2024 | i-ekb.ru
Запчасти для автомобилей значительно подорожали Цены на запчасти с начала 2024 года выросли почти на четверть, подсчитали аналитики «Ренессанс страхования». Больше всего — почти вдвое — подорожали …
20:11, октября 28, 2024 | banki.ru
В партии абхазской мимозы Карантинная служба России нашла калифорнийского трипса Экспортную партию мимозы (акации серебристой) не пропустила на абхазо-российской границе Карантинная служба России. В мимозе был обнаружен калифорний …
00:11, февраля 25, 2025 | eadaily.com
Apple теперь продает запчасти для iPhone 16 и 16 Pro Американская корпорация Apple начала продавать оригинальные запчасти для ремонта смартфонов iPhone 16 и 16 Pro. Об этом сообщает The Verge.Пользовате …
20:11, ноября 11, 2024 | finam.ru
КМЗ импортозаместит запчасти для турбин Siemens на 500 млн рублей Военно-промышленный холдинг «Кингисеппский машиностроительный завод» (КМЗ; входит в структуру ОСК), приступил к реализации проекта по импортозамещени …
00:11, сентября 23, 2025 | kommersant.ru
Продавал память со скидкой за откаты. Samsung инициировала внутреннее расследование в связи с нарушениями со стороны своих сотрудников Кризис на рынке памяти уже достиг таких масштабов, что Samsung инициировала расследование внутри компании, так как подозревает, что её сотрудники пол …
00:11, декабря 19, 2025 | ixbt.com
Bloomberg узнал о передаче Украине новой партии Storm Shadow для ударов по России Лондон недавно отправил Киеву дополнительное количество крылатых ракет Storm Shadow, сообщили источники Bloomberg. Конкретного числа переданных ракет …
20:11, ноября 3, 2025 | forbes.ru
Запчасти для китайских машин подорожали в полтора раза Средний рост стоимости оригинальных запасных частей для легковых автомобилей производства КНР за год составил 45%. Продавцы деталей ссылаются на паде …
20:11, сентября 16, 2024 | versia.ru
Как найти нужные запчасти для велосипеда: Полное руководство Все мы любим кататься на велосипеде, будь то для удовольствия, занятий спортом или как удобное средство передвижения. Но что делать, когда велосипед …
00:11, июля 3, 2024 | astera.ru
Запчасти на «китайцев» в 2025 году могут подорожать на 15-20% Руководитель сервисного направления автомобильного маркетплейса Fresh Александр Носко рассказал «Ъ» о ситуации с обслуживанием китайских автомобилей. …
20:11, декабря 12, 2024 | kommersant.ru
В России успешно прошло корпусирование опытной партии микросхем по редкой мало освоенной технологии Компания GS Nanotech провела корпусирование опытной партии микросхем по технологии «флип-чип». Серийно таким методом микросхемы в России пока еще не …
10:11, июля 2, 2024 | zoom.cnews.ru
«Единой России» засчитали Москву // Эксперты предсказали партии уверенную победу на выборах в Мосгордуму От 35 до 42 (из 45) мандатов в Мосгордуме по итогам осенних выборов получат кандидаты от «Единой России» — такой прогноз дали в среду эксперты на бри …
10:11, августа 29, 2024 | kommersant.ru
Apple станет официально поддерживать неофициальные запчасти для iPhone Apple опубликовала на своем сайте важную информацию о ремонте iPhone. Теперь компания не будет ограничивать функциональность смартфона, если пользова …
10:11, июня 29, 2024 | astera.ru
«Коммерсантъ» узнал о планах «Аэрофлота» приобрести самолеты на запчасти «Аэрофлот» обсуждает со структурой группы «Волга-Днепр» передачу пяти самолетов, узнал «Коммерсантъ». По данным газеты, самолеты могут потребоваться …
10:11, декабря 6, 2024 | forbes.ru
Распался на запчасти // Производитель автомобильных компонентов JSS продает бизнес в РФ Иностранные производители автомобильных компонентов продолжают сокращать присутствие в РФ. Поставщик рулей, ремней, подушек безопасности Joyson Safet …
00:11, сентября 6, 2024 | kommersant.ru
Почему запчасти для iPad у Apple стоят как новый планшет Apple наконец-то разрешила пользователям в США и некоторых других странах самостоятельно ремонтировать iPad, но радоваться этому точно не стоит. Цены …
05:11, августа 2, 2025 | appleinsider.ru
Honda выставляет на аукцион запчасти гоночных реликвий Формулы-1 Фанаты смогут купить кусочек истории Формулы-1 и не только — Honda Racing Corporation (HRC) решила расстаться с частью своего легендарного насл …
00:11, апреля 3, 2025 | itzine.ru
Apple начала продавать запчасти для самостоятельного ремонта iPhone 16 Компания Apple начала продавать некоторые запчасти для самостоятельного ремонта смартфонов iPhone 16. …
05:11, ноября 15, 2024 | i-ekb.ru
«Единой России» помогут свыше // Большинство списков партии на выборах в региональные парламенты возглавят губернаторы Региональные отделения политических партий приступили к выдвижению своих списков на выборы законодательных собраний. В этом году они пройдут в 13 суб …
10:11, июля 1, 2024 | kommersant.ru
Эксперт Kaspersky сообщил, когда Apple блокирует «серые» запчасти Apple давно использует функцию блокировки неофициальных запчастей, сообщил Владимир Дащенко из Kaspersky ICS CERT в беседе с «РИА Новости». …
15:11, сентября 14, 2024 | astera.ru
«Старые планеры идут на запчасти»: британские войска испытывают серьёзные трудности Чтобы построить «Глобальную Британию», необходимы сильные войска, но их состояние продолжает ухудшаться …
10:11, сентября 19, 2024 | topwar.ru
Дилер поставил на автомобиль Geely неоригинальные запчасти и оставил его владельца без гарантии Петербургский предприниматель столкнулся с необычной ситуацией, лишившись гарантийного обслуживания на автомобиль Geely Monjaro по вине официального …
20:11, октября 22, 2025 | versia.ru
Антон Алиханов: в США заблокированы оплаченные Россией запчасти на сотни миллионов долларов В Минпромторге высказались относительно западных санкций, которые распространяются на авиационную отрасль. В частности, там сообщили, что в США остаю …
10:11, апреля 2, 2025 | versia.ru
Кроссовер за 1,95 млн рублей с «автоматом» стал хитом в России: первая партия Forthing T5 раскуплена, все машины из второй партии забронированы Ixen Motors Rus — дистрибутор марки Forthing — рассказала о большом спросе на кроссовер Forthing T5, продажи которого начались в середине …
20:11, октября 4, 2024 | ixbt.com
Сбербанк получил $105 млн от британской «дочки» Банк смог исполнить судебное решение и изъял деньги британской компании, которые были на счетах в самом банке и Национальном расчетном депозитарии. …
00:11, ноября 10, 2024 | pravo.ru
Какие запчасти понадобятся, чтобы собрать FPV квадрокоптер: полный список и практическое руководство Сборка FPV (First Person View) квадрокоптера — задача, требующая внимания к деталям, понимания совместимости компонентов и базовых навыков пайки. Есл …
10:11, сентября 5, 2025 | astera.ru
Сбербанк взыскал 11,9 млрд руб. с британской «дочки» В отношении дочерней компании российского банка, Sberbank CIB (UK) Limited, введена временная администрация. …
10:11, июня 25, 2024 | pravo.ru
На крупнейшей британской верфи произошел пожар В среду, 30 октября, начался пожар на судостроительном комплексе крупнейшей оборонной компании Великобритании BAE Systems в городе Барроу-ин-Фернесс. …
00:11, октября 31, 2024 | военное.рф
Раскрыто высказывание британской королевы о Путине В новой биографии королевы Великобритании Елизаветы II раскрыто высказывание, которое она сделала в адрес президента России Владимира Путина. Об этом …
00:11, августа 29, 2024 | news.rambler.ru
Из британской армии массово увольняются военнослужащие Стало известно, что тысячи человек уволились из армии Великобритании в прошлом году. Такая тенденция обусловлена низкими зарплатами. При этом правите …
10:11, декабря 22, 2024 | versia.ru
Прокуратура подала иск к британской энергокомпании Shell Заявление связано с нефтегазовым проектом «Сахалин-2», так как третьими лицами по делу привлекают «Газпром экспорт» и «Сахалинскую энергию». …
15:11, октября 5, 2024 | pravo.ru
«Никто задачи чистки точно не ставил» // Секретарь генсовета «Единой России» Владимир Якушев — о переменах в партии, «паровозах» и выборах в Госдуму Год назад секретарем генерального совета «Единой России» (ЕР) был назначен Владимир Якушев. В этой должности он отвечает за оперативное управление па …
00:11, июня 16, 2025 | kommersant.ru
Не так уж и дорого: после первого Aurus Komendant с пробегом на разборке появились запчасти для редкой модели На одной из московских авторазборок появились в продаже блок-фары от подержанного внедорожника Aurus Komendant. Предположительно, эти детали принадле …
10:11, марта 22, 2025 | ixbt.com
Британской учительнице, родившей от ученика, запретили преподавать В Великобритании учительницу, осужденную за сексуальные отношения с двумя школьниками и беременность от одного из них, лишили права заниматься профес …
05:11, декабря 26, 2025 | gazeta.ru
Жуткие последствия вейпинга: история британской девушки Вейпинг разрушает легкие человека и ученые находят этому все больше доказательств. Источник: woodsidedenturecentre.com Согласно статистике, в 2024 го …
00:11, июля 5, 2024 | hi-news.ru
Суд взыскал 11,9 млрд руб. в пользу Сбербанка с его британской «дочки» Арбитражный суд Москвы удовлетворил иск Сбербанка (MOEX: SBER) к его бывшей британской «дочке» Sberbank CIB (UK) Limited. По решению суда с нее взыск …
00:11, июня 25, 2024 | kommersant.ru
Карл III заявил, что не против выхода Австралии из-под британской короны Король Великобритании Карл III не будет возражать, если Австралия решит провозгласить себя республикой и перестанет считать его главой государства, п …
05:11, октября 13, 2024 | eadaily.com
Экс-фронтмен культовой британской рок-группы попал в жюри «Интервидения» от США В жюри международного песенного конкурса «Интервидение» США представит культовый вокалист с полувековой карьерой Джо Линн Тернер. Об этом сообщили ор …
10:11, сентября 18, 2025 | eadaily.com
В британской тюрьме выявили высокую концентрацию радиоактивного элемента Тюрьму в британском Дартмуре временно закрыли из-за выявленной высокой концентрации радиоактивного радона. Об этом сообщает Sky News. В здании отбыва …
05:11, июля 18, 2024 | gazeta.ru
«Грабеж и убийства»: Захарова раскрыла суть британской короны Официальный представитель МИД России Мария Захарова в своем Telegram-канале в ответ на призыв экс-премьера Британии Риши Сунака как можно скорее похи …
05:11, марта 17, 2025 | news.rambler.ru
Небезопасные связи: концерт британской поп-звезды отменили в Стамбуле Концерт бывшего участника бойсбенда Take That, британского исполнителя Робби Уильямса отменили в Стамбуле решением администрации провинции. Об этом с …
05:11, октября 6, 2025 | eadaily.com
Сотрудников британской оборонки предупредили об угрозе китайского шпионажа Военно-промышленные компании Великобритании вводят новые ограничения для своих сотрудников, опасаясь стать жертвами промышленного шпионажа. Как сообщ …
20:11, апреля 29, 2025 | военное.рф
Не Джеймсы Бонды — у британской разведки колоссальный провал в Москве Британская разведка — это обычные чиновники, заявил генерал-майор ФСБ Александр Михайлов, комментируя то, что шестерых британских дипломатов лишили а …
00:11, сентября 14, 2024 | eadaily.com
Военный эксперт предложил ударить по британской базе в Европе Россия может нанести удар с территории Сирии по военной базе Великобритании на Кипре в качестве ответа на атаки Вооруженных сил Украины (ВСУ) по Росс …
10:11, июня 19, 2024 | gazeta.ru
В британской Mirror дошли до пророчеств Ванги: «Европа превратится в пустыню» Бет Харди, обозревательница светской хроники из The Mirror, в отсутствие новостей решила напомнить про загадочную Бабу Вангу, которая с ужасающей точ …
10:11, сентября 15, 2025 | eadaily.com
В британской больнице выходец из Афганистана ранил ломом пять человек По данным правоохранительных органов, 20-летний мужчина обратился в больницу, однако когда ему отказали в приеме у врача и попросили покинуть лечебно …
00:11, декабря 31, 2025 | tass.ru
В Великобритании заявили о неготовности британской армии к конфликту любого масштаба Вооруженные силы Великобритании не смогут защитить страну в случае серьезной угрозы, поскольку оборона слишком слаба для конфликта любого масштаба. …
10:11, июля 1, 2024 | news.rambler.ru
Несмотря на повышение зарплат, из британской армии увольняются тысячи военнослужащих Стремясь удержать в армии личный состав, британское Минобороны было вынуждено пойти на значительное повышение зарплат военнослужащих …
00:11, декабря 24, 2024 | topwar.ru
Конгрессвумен Марджори Грин посоветовала британской журналистке вернуться домой Американская конгрессвумен-республиканка Марджори Тейлор Грин в резкой форме ответила корреспонденту британского телеканала, посоветовав ей вернуться …
00:11, марта 28, 2025 | versia.ru
Ассанж вышел на свободу из британской тюрьмы в рамках сделки с Минюстом США Высокий суд Лондона освободил под залог основателя WikiLeaks Джулиана Ассанжа, и он вылетел на родину в Австралию. В тюрьме журналист провел 1901 ден …
10:11, июня 25, 2024 | forbes.ru
ВТБ списал через суд 5 млрд руб. со счетов своей бывшей британской «дочки» Банк ВТБ (MOEX: VTBR) взыскал задолженности по кредитам со своей бывшей дочерней компании VTB Capital по решению Арбитражного суда Санкт-Петербурга. …
15:11, января 13, 2025 | kommersant.ru
В британской армии может быть сформирован полк из украинцев — Telegraph Правительство Великобритании обсуждает вопрос о формировании в составе королевской армии специального полка, состоящего из украинцев. …
15:11, января 18, 2025 | eadaily.com
В посольстве высказались о поездке журналистки британской Times в Курскую область Россия закроет въезд для журналистки британской газеты Times Кэтрин Филп после ее поездки в город Суджа, расположенный в Курской области. Об этом зая …
05:11, августа 31, 2024 | gazeta.ru
Начальник Генштаба Британии признал недостаточную боеспособность британской армии Вооруженные силы Великобритании недостаточно подготовлены для защиты страны в случае крупного конфликта. Об этом заявил начальник британского Генштаб …
20:11, января 12, 2026 | gazeta.ru
Джулиана Ассанжа выпустили из британской тюрьмы после 1901 дня ареста Высокий суд Лондона отпустил его под залог. Основатель WikiLeaks сразу сел на самолёт и улетел в Австралию. Об этом организация сообщила на своей стр …
15:11, июня 25, 2024 | secretmag.ru
«Аэробус» от старейшей британской компании и Geely поступил в продажу в Китае Geely объявила о начале поставок минивэна LEVC L380 в четырех версиях по цене от 52 300 до 66 000 долларов. LEVC — это 116-летняя London Electr …
15:11, июля 25, 2024 | ixbt.com
Карл III не будет противиться выходу Австралии из-под британской короны — Daily Mail Король Великобритании Карл III не будет препятствовать, если Австралия решит стать республикой. Об этом говорится в письме Букингемского дворца Австр …
05:11, октября 13, 2024 | eadaily.com
Экономисты оценили потери британской экономики из-за новых тарифных угроз Трампа Британская экономика окажется под угрозой рецессии из-за обещанных президентом США дополнительных импортных пошлин, предупредили экономисты. По их оц …
10:11, января 20, 2026 | forbes.ru
Медведев: Активы будем возмещать территориями Украины и ценностями британской короны Захваченные у России Западом активы Москва будет компенсировать в «натуральной форме» — новыми территориями и имуществом. Так зампред Совбеза России …
15:11, сентября 4, 2025 | eadaily.com
Утренний обзор за 1 ноября: стандарт кредитного страхования и выплаты британской «дочки» Сбера Минфин подготовил проект постановления, которое устанавливает порядок передачи маркетплейсами информации о налоговых рисках продавцов. Британская «до …
20:11, ноября 1, 2025 | pravo.ru
iFixit начали продавать запчасти для Xbox Series X и Series S Сервис по разбору и ремонту гаджетов iFixit начал продажи оригинальных запчастей для Xbox Series X и Series S. Теперь владельцы приставок могут самос …
10:11, декабря 9, 2024 | ichip.ru
В США признали проблемы с отправкой вооружений ВСУ Соединенные Штаты сталкиваются с проблемами при отправке Украине вооружений и военной техники, признала постпред США при при НАТО Джулианн Смит. Об э …
00:11, июня 28, 2024 | news.rambler.ru
Финляндия нарастила экспорт вооружений Согласно отчету аналитического центра по вопросам мира и безопасности SaferGlobe, в прошлом году Финляндия экспортировала оружие военного и гражданск …
15:11, октября 22, 2024 | военное.рф
Париж готовится к гонке вооружений Франция готовится к гонке вооружений с Россией, наращивая военный бюджет. Об этом заявил глава МИД Франции Жан-Ноэль Барро в интервью телеканалу LCI. …
15:11, октября 20, 2024 | военное.рф
В МИД РФ прокомментировали заявления США о контроле вооружений Официальный представитель МИД РФ Мария Захарова назвала однобокими заявления США о том, что Россия увязывает диалог по контролю над вооружениями с пр …
10:11, июля 31, 2024 | gazeta.ru
Мировые державы втягиваются в гонку вооружений Самыми ударными темпами движется Китай: к 2030 году его ядерный потенциал вырастет впятеро, отмечают в Пентагоне. Всего, считают в США, у китайцев по …
20:11, ноября 11, 2024 | versia.ru
В США заявили о начале новой гонки вооружений Новая гонка вооружений между США, Россией и Китаем уже началась. Об этом сообщает газета The Wall Street Journal (WSJ). …
10:11, ноября 17, 2025 | news.rambler.ru
«Рособоронэкспорт» отметил 25 лет работы на рынке вооружений 4 ноября исполнилось 25 лет со дня создания «Рособоронэкспорта» — государственного посредника по экспорту вооружений (сейчас входит в госкорпорацию « …
10:11, ноября 5, 2025 | kommersant.ru
В Сербии объяснили отказ от российских вооружений Западные санкции, введенные против России, не позволяют осуществлять поставки вооружений из Москвы и вынудили Сербию расторгнуть заключенные ранее ко …
20:11, января 9, 2025 | военное.рф
Израиль рекордно нарастил экспорт вооружений По итогам 2024 года экспорт израильских вооружений и военной техники достиг исторического максимума и составил 14,7 млрд долларов. Об этом сообщает T …
15:12, июня 6, 2025 | военное.рф
SIPRI назвал крупнейших экспортеров вооружений Россия заняла третье место в мире по объемам экспортируемого оружия в 2020–2024 годах. Об этом сообщает РБК со ссылкой на доклад Стокгольмского между …
00:11, марта 11, 2025 | военное.рф
Трамп оценил запасы вооружений Украины Украине может хватить вооружений для продолжения боевых действий как минимум до достижения Вашингтоном и Москвой договоренности по урегулированию рос …
05:11, февраля 26, 2025 | eadaily.com
Call of Duty: Black Ops 6 в британской рознице стартовала хуже MWIII — во многом из-за включения игры в Game Pass Black Ops 6 возглавила еженедельный чарт самых продаваемых игр в Великобритании на физических носителях, согласно данным GfK. Однако запуск игры оказ …
00:11, октября 31, 2024 | app2top.ru
Франция решила включиться в гонку вооружений в космосе Власти Франции выделят только 4,2 млрд евро на оборону в космосе. Об этом 12 ноября заявил президент страны Эммануэль Макрон. …
10:11, ноября 13, 2025 | eadaily.com
Глава Еврокомиссии призвала начать гонку вооружений Глава Еврокомиссии Урсула фон дер Ляйен считает, что необходимо срочно вооружить Европу. Об этом она заявила журналистам после встречи европейских ли …
15:11, марта 3, 2025 | военное.рф
Шольц призвал остановить «бесконечное наращивание вооружений» Действующий канцлер Германии и кандидат от социал-демократов на предстоящих досрочных выборах Олаф Шольц призвал положить конец бесконечному наращива …
05:11, февраля 12, 2025 | eadaily.com
Ведяхин сравнил развитие ИИ с гонкой ядерных вооружений В мире формируется новый "ИИ-клуб", сравнимый по значимости с "ядерным клубом" XX века. Об этом "Ведомостям" заявил первый заместитель председателя п …
10:11, декабря 18, 2025 | gazeta.ru
Посол указал на истощение запасов вооружений Норвегии для ВСУ Запасы вооружений Норвегии для поставок украинской армии близки к истощению, в связи с чем возрастает роль закупок нового оружия у местного и западно …
15:11, ноября 30, 2024 | news.rambler.ru
В Марселе протестующие заблокировали завод по производству вооружений В Марселе манифестанты заблокировали завод по производству вооружений французской компании Eurolinks. Об этом сегодня, 18 сентября, сообщила депутат …
15:11, сентября 18, 2025 | eadaily.com
Глава "Ростеха" допустил приостановку экспорта вооружений Консервативная финансовая политика в России может привести к стагфляции, "Ростех" может остановить экспорт высокотехнологичной продукции из-за высоко …
05:11, октября 25, 2024 | военное.рф
Путин проведет совещание на тему госпрограммы вооружений Президент России Владимир Путин проведет сегодня совещание на тему развития оборонно-промышленного комплекса страны. Этот вопрос будет обсуждаться в …
20:11, декабря 26, 2025 | kommersant.ru
Новые образцы вооружений и техники на параде в Китае На параде 3 сентября китайская армия показала свои вооружения и технику. Некоторые из представленных образцов впервые присутствовали на публичном мер …
10:11, сентября 5, 2025 | topwar.ru
Шольц призвал предотвратить «бесконечное наращивание вооружений» Канцлер ФРГ Олаф Шольц призвал предотвратить «бесконечное наращивание вооружений». Он подчеркнул, что, несмотря на конфликт на Украине, нужно возвращ …
05:11, февраля 12, 2025 | news.rambler.ru
Шольц анонсировал дополнительную поставку вооружений для Украины В августе немецкие СМИ писали, что Германия вынуждена сократить объёмы военной помощи Украине, поскольку, согласно текущему бюджетному планированию п …
05:11, декабря 3, 2024 | versia.ru
Мали поблагодарила Россию за оперативные поставки вооружений Глава МИД Мали Абдулай Диоп заявил, что страна высоко ценит оперативность поставок военной техники, закупаемой у России. Его слова приводит РИА Новос …
05:11, октября 4, 2024 | news.rambler.ru
Украина получит новую партию вооружений от Эстонии Украина получит партию пусковых установок и ракеты для ЗРК (зенитно-ракетного комплекса) Mistral от Эстонии. Об этом сообщает РИА Новости со ссылкой …
17:32, июня 11, 2024 | gazeta.ru
«Испугались ракет Путина»: украинские «активисты» комментируют публикацию британской прессы о нежелании направлять сухопутные войска на Украину Британская пресса со ссылкой на источники пишет, что Лондон отказывается отправлять войска на Украину …
00:11, апреля 25, 2025 | topwar.ru
Италия прекратила выдачу лицензий на экспорт вооружений Израилю Италия приостановила выдачу новых лицензий на экспорт Израилю любых вооружений с начала операции еврейского государства в секторе Газа после атаки ра …
10:11, октября 17, 2024 | военное.рф
В Кремле заявили, что Россия не станет участником гонки вооружений Российская Федерация не поддастся на провокацию Польши и не станет участником гонки вооружений. Об этом заявил пресс-секретарь президента РФ Дмитрий …
05:11, марта 7, 2025 | news.rambler.ru
В Молдавии планируют построить логистический хаб для переправки вооружений на Украину На строительство инфраструктуры транспортного хаба для переправки вооружений из Румынии на Украину выделено 30 миллионов евро …
20:11, июля 19, 2024 | topwar.ru
Найдена старейшая эволюционная гонка вооружений возрастом 517 миллионов лет Исследователи обнаружили самый древний из известных примеров эволюционной гонки вооружений в окаменелостях, которым 517 миллионов лет. Эта битва «хищ …
05:11, января 7, 2025 | ferra.ru
Представитель МИД РФ: Москва не допустит получения Киевом ядерных вооружений Высказывания украинских политиков о возможности получения Киевом ядерного оружия могут трактоваться как заявка на пересмотр безъядерного статуса Укра …
05:11, декабря 6, 2024 | topwar.ru
Кривонос заявил о зависимости Украины от иностранных поставок вооружений Сергей Кривонос выразил мнение, что Украина стала зависимой от иностранных поставок, особенно из США, из-за недовыполненного «домашнего задания» по п …
05:11, марта 5, 2025 | news.rambler.ru
Лондон выделил Киеву 2,7 млрд долларов на покупку вооружений Лондон выделил Киеву более 2 млрд фунтов стерлингов (свыше $ 2,7 млрд) на покупку вооружений через возглавляемый Великобританией Международный фонд п …
05:11, сентября 10, 2025 | eadaily.com
СМИ: Израиль давит на Вашингтон, чтобы ускорить поставки вооружений Израиль усиливает давление на администрацию президента США Джо Байдена и законодателей Конгресса, чтобы ускорить получение разрешения на поставки ору …
05:11, июля 28, 2024 | военное.рф
Найдена старейшая эволюционную гонка вооружений возрастом 517 миллионов лет Исследователи обнаружили самый древний из известных примеров эволюционной гонки вооружений в окаменелостях, которым 517 миллионов лет. Эта битва «хищ …
00:11, января 6, 2025 | ferra.ru
В Пентагоне заявили, что могут производить больше вооружений, чем Россия Соединенные Штаты могут производить больше вооружений, чем Россия, но для этого потребуется время и синергия ряда факторов. Об этом заявил председате …
05:11, июля 20, 2024 | gazeta.ru
Трамп: мы изучаем вопрос дальнейших поставок вооружений Украине Власти Соединенных Штатов изучают возможность дальнейших поставок оружия и военной техники Украине. Об этом заявил президент США Дональд Трамп в ходе …
10:11, января 23, 2025 | военное.рф
Politico: Великобритания запретила Израилю участвовать в выставке вооружений Власти Великобритании отстранили представителей Израиля от участия в крупной выставке вооружения DSEI в Лондоне из-за ситуации в секторе Газа, сообща …
05:11, августа 29, 2025 | eadaily.com
Госдеп подтвердил снятие ограничений на продажу вооружений Эр-Рияду Администрация Соединенных Штатов снимает ограничения на продажу Саудовской Аравии некоторых боеприпасов класса «воздух-земля». Об этом сообщил коррес …
05:11, августа 10, 2024 | news.rambler.ru
У Ирана нет ограничений на поставки вооружений другим странам — постпредство в ООН Постоянное представительство Ирана при ООН заявляет, что юридически на Тегеран не распространяются никакие ограничения или запреты в отношении покупк …
00:11, августа 12, 2024 | eadaily.com
САУ и бронетехника: Азербайджан может передать ВСУ остатки советских вооружений Если Алиев снимет эмбарго, Баку может передать Киеву остатки доставшихся от СССР артиллерийских систем и БТР …
10:11, августа 12, 2025 | topwar.ru
Парламентарии Швейцарии готовы смягчить ограничения на экспорт вооружений Комиссия по политике безопасности Национального совета, нижней палаты парламента Швейцарии, одобрила смягчение закона о поставках и реэкспорте вооруж …
20:11, ноября 13, 2025 | военное.рф
США сняли запрет на поставки вооружений нацистскому формированию «Азов»* Администрация президента США Джо Байдена сняла запрет на поставки вооружений украинскому националистическому формированию «Азов»*. …
07:32, июня 11, 2024 | eadaily.com
Биологи усомнились в неизбежной победе бактерий в «гонке вооружений» с антибиотиками Европейские молекулярные биологи проанализировали, как менялся уровень стойкости бактерий к антибиотикам в 30 странах в последние два десятилетия, и …
00:11, апреля 4, 2025 | news.rambler.ru
Недовольная пошлинами Трампа Индия остановила закупку вооружений у США — Reuters Индия приостановила запланированные закупки нового оружия и самолетов у США, сообщает агентство Reuters со ссылкой на трех индийских чиновников, знак …
00:11, августа 9, 2025 | eadaily.com
Германия значительно сократила выдачу разрешений на поставку вооружений на Украину Германия значительно сократила выдачу разрешений на поставки вооружений на Украину. Об этом сообщает N-TV. В публикации отмечается, что в 2025 году э …
15:11, декабря 29, 2025 | gazeta.ru
Остин: отдельные системы вооружений не помогут Киеву изменить ход конфликта По словам главы оборонного ведомства США Ллойда Остина, ни один вид вооружений в отдельности не сможет помочь ВСУ переломить ход боевых действий на У …
00:11, ноября 2, 2024 | versia.ru
Путин призвал не ставить новые системы вооружений «в чистом поле» Президент Владимир Путин провел совещание по вопросам государственной программы вооружений. Глава государства подчеркнул, что под новые системы нужно …
10:11, июня 12, 2025 | kommersant.ru
«Рособоронэкспорт» обсудил на LAAD 2025 планы совместного производства вооружений В рамках Международной латиноамериканской выставки авиационных и оборонных систем (LAAD 2025), которая прошла с 1 по 4 апреля в бразильском Рио-де-Жа …
10:11, апреля 5, 2025 | kommersant.ru
Запад рисует картины ядерного апокалипсиса для оправдания гонки вооружений Британская пресса в очередной раз порадовала публику мрачными фантазиями о «российском ядерном ударе», живописуя картины, достойные дешёвых постапока …
15:11, ноября 17, 2025 | topwar.ru
Трамп опроверг сообщения СМИ об упразднении базы в Греции для поставок вооружений Президент Соединённых Штатов Дональд Трамп на пресс-конференции по итогам встречи с французским лидером Эммануэлем Макроном опроверг появившиеся в СМ …
00:11, февраля 26, 2025 | versia.ru
Владимир Путин предложил проанализировать важнейшие параметры программы вооружений Президент Российской Федерации Владимир Путин на совещании, посвящённом реализации государственной программы вооружений, предложил провести детальный …
05:11, июня 12, 2025 | versia.ru
Мексика выступила против выделения миллионов на поставки вооружений на Украину Гонка вооружений беспокоит Мексику, страна выступает против выделения миллионов долларов на поставки вооружений на Украину. С таким заявлением выступ …
20:11, сентября 27, 2024 | news.rambler.ru
Украинец готовил подрыв ж/д путей в Краснодаре для срыва поставок вооружений на СВО Предотвращен планировавшийся по заданию украинских спецслужб подрыв железнодорожных путей в Краснодаре для срыва графика перевозок военной техники и …
15:11, ноября 22, 2025 | eadaily.com
Путин увеличил количество стипендий за прорывные разработки в области вооружений Президент России Владимир Путин подписал указ об увеличении количества стипендий для молодых ученых и конструкторов. Они будут выдаваться за прорывны …
20:11, августа 31, 2025 | kommersant.ru
Шатдаун в США привёл к задержкам поставок вооружений союзникам по НАТО и Украине Приостановка работы федерального правительства США (шатдаун) вызвала перебои в экспорте американских вооружений странам-союзницам по НАТО, а также Ук …
15:11, ноября 10, 2025 | versia.ru
Петербургский производитель покажет на "Армии-2024" комплектующие для перспективных вооружений В международном военно-техническом форуме "Армия-2024" примет участие петербургская фирма "ОмегаТех", которая специализируется на изготовлении сложны …
10:11, июля 21, 2024 | военное.рф
Зеленский запросил у США в рамках сделки по ископаемым пакет вооружений на $ 50 млрд Украина готова купить у США пакет оружия на сумму 30−50 млрд долларов. Об этом заявил глава киевского режима Владимир Зеленский, сообщает «РБК — Укра …
00:11, апреля 10, 2025 | eadaily.com
Власти Сербии расторгли заключенные с Россией контракты на поставку вооружений Введенные против РФ странами Запада санкции не позволяют Белграду получать российские вооружения, поэтому Сербия вынуждена расторгнуть заключенные ра …
20:11, января 8, 2025 | eadaily.com
Эр-Рияд сближается с Пекином — дело может дойти до закупки китайских вооружений Китайцы будут пытаться играть проактивную роль на Ближнем Востоке, заполняя вакуум влияния, который оставляют после себя в регионе Соединенные Штаты. …
05:11, июня 28, 2024 | eadaily.com
Ереван предложил Баку создать механизм взаимного контроля и верификации вооружений Армения и Азербайджан «очень близки к завершению проекта мирного соглашения». Об этом в интервью индийскому изданию WION в рамках официального визита …
20:11, марта 11, 2025 | eadaily.com
40% вооружений: военный эксперт рассказал, какого оружия США могут лишить Украину Обозреватель издания Ferra.ru Павел Воронов в статье «Какого оружия лишится Украина в ближайшее время» рассказал, какой объём и какого вооружения мож …
05:11, марта 3, 2025 | ferra.ru
Путин призвал уделить особое внимание ядерному оружию в госпрограмме вооружений Президент России Владимир Путин начал серию специальных рабочих совещаний, посвященных государственной программе вооружений. На встрече глава государ …
10:11, июня 12, 2025 | kommersant.ru
Карнавал вооружений // Россия готовится к возвращению на оборонный рынок Латинской Америки В Бразилии завершилась крупная по региональным меркам выставка вооружений и систем двойного назначения LAAD 2025, на которой «Рособоронэкспорт» предс …
00:11, апреля 8, 2025 | kommersant.ru
Замсекретаря Совбеза РФ: Финляндия станет площадкой для размещения ударных вооружений НАТО Нургалиев подчеркнул, что в стремлении взять реванш за разгром своей армии в 1944 году Хельсинки активно поддерживает украинских нацистов и соглашает …
20:11, июня 27, 2024 | topwar.ru
Офицер ПВО с позывным «Граф» рассказал о применении передовых систем вооружений в зоне спецоперации В отличие от вооруженных конфликтов даже недавнего прошлого, технологии и инновации все больше становятся определяющими компонентами для достижения п …
10:11, апреля 1, 2025 | versia.ru
Экспансия китайских объектовых систем ПВО средней и большой дальности на мировом рынке вооружений В настоящее время Китай серьёзно потеснил Россию на мировом рынке вооружений, продавая ЗРК средней и большой дальности в страны, которые раньше ориен …
05:11, января 23, 2025 | topwar.ru
На саммите НАТО в Вашингтоне ключевым станет вопрос увеличения производства вооружений и боеприпасов для Украины Автор статьи в Defense News считает, что страны НАТО должны в полной мере «снабжать Украину необходимыми инструментами для победы в войне» с Россией …
20:11, июля 6, 2024 | topwar.ru
Главное в военных СМИ за неделю: экспорт вооружений под угрозой, развитие производства беспилотников, возможности верфей ограничены Для специалистов и руководителей оборонно-промышленного комплекса аналитики Mil.Press подготовили дайджест публикаций прессы за неделю с 21 по 25 окт …
10:11, октября 26, 2024 | военное.рф
В США заявили о хаосе в Демократической партии Американский миллиардер Дэвид Сакс заявил, что в Демократической партии США воцарился хаос после неудачного выступления главы государства Джо Байдена …
10:11, июля 6, 2024 | versia.ru
Минюст подал иск в ВС о ликвидации «Партии дела» Она будет оспаривать это решение, а руководители фракции ЛДПР ждут ее представителей в Госдуме следующего созыва …
20:11, октября 21, 2024 | vedomosti.ru
Минюст подал иск о ликвидации Партии дела В Верховный суд поступил иск о ликвидации Партии дела. Рассмотрение заявления Минюста назначено на 27 ноября, сообщили ТАСС в суде. …
00:11, октября 20, 2024 | kommersant.ru
СМИ сообщили об обысках в офисе партии Тимошенко В офисе партии "Батькивщина" экс-премьер-министра Украины Юлии Тимошенко проводятся следственные мероприятия. Об этом сообщает издание "Украинская пр …
05:11, января 14, 2026 | gazeta.ru
Шах и мат для партии Саакашвили: «Грузинская мечта» нейтрализовала Евросоюз Заключение временной следственной комиссии по расследованию деятельности режима «Единого национального движения» и его политических деятелей в 2003—2 …
00:11, сентября 8, 2025 | eadaily.com
ЕС пригрозил Грузии — от партии Саакашвили избавляться нельзя ЕС предупреждает, что планы правительства Грузии «объявить оппозиционные партии вне закона после октябрьских парламентских выборов разрушат то, что о …
00:11, августа 28, 2024 | eadaily.com
В США раскрыли последствия прихода партии Ле Пен к власти во Франции Приход к власти во Франции партии Марин Ле Пен "Национальное объединение" станет поражением Эммануэля Макрона и катастрофой для Запада. Такую оценку …
10:11, июля 2, 2024 | gazeta.ru
СМИ: США тайно внедряют трекеры в партии ИИ-чипов Nvidia и AMD По информации СМИ, американские власти тайно размещают устройства для отслеживания местоположения в партиях чипов, которые могут быть незаконного пер …
00:11, августа 16, 2025 | xakep.ru
Трамп заявил о перевороте внутри Демократической партии США Кандидат в президенты США Дональд Трамп заявил в интервью телеканалу Fox News, что действующего американского лидера Джо Байдена отстранили от выборо …
20:11, августа 2, 2024 | gazeta.ru
Лидер российской партии посвятил «Орешнику» стихотворение Лидер партии «Справедливая Россия — За правду» Сергей Миронов посвятил стихотворение баллистической ракете средней дальности «Орешник». Трансляция вы …
15:11, декабря 18, 2024 | news.rambler.ru
Лидер КПРФ Зюганов указал на противников партии Решивший идти в губернаторы толстосум Роман Лябихов, очевидно, пользуется покровительством боссов Компартии. Что неудивительно, ведь для КПРФ тесное …
20:11, июля 1, 2025 | versia.ru
Вассерман объяснил победу партии Санду на выборах Партия «Действие и солидарность», возглавляемая президентом Молдавии Майей Санду, смогла одержать победу на парламентских выборах благодаря трем факт …
20:11, сентября 29, 2025 | news.rambler.ru
В США подожгли отделение Республиканской партии в штате Нью-Мексико Отделение Республиканской партии США подожгли в штате Нью-Мексико, сообщает телеканал CBS со ссылкой на председателя отделения. …
10:11, марта 31, 2025 | eadaily.com
Иран заявил о перехвате партии оборудования Starlink Иранские разведывательные службы сообщили о задержании крупной партии комплектов спутниковой связи Starlink в приграничной зоне. Власти утверждают, ч …
00:11, января 14, 2026 | gazeta.ru
Ле Пен и верхушку ее партии судят за растрату денег Евросоюза В Париже начался суд над лидером «Национального объединения» Марин Ле Пен и высокопоставленными представителями партии, которых обвиняют в растрате д …
05:11, октября 1, 2024 | eadaily.com
Тбилисский суд арестовал лидера оппозиционной партии «Гирчи» Тбилисский городской суд приговорил одного из лидеров оппозиционной «Коалиции за перемены», лидера партии «Гирчи» Зураба Джапаридзе к аресту в качест …
20:11, мая 23, 2025 | eadaily.com
Глава партии Ле Пен предрек год политической нестабильности во Франции В партии "Национальное объединение", неформальным лидером которого является Марин Ле Пен, считают, что после недавних парламентских выборов Франция п …
20:11, июля 8, 2024 | gazeta.ru
В партии «Зеленые» раскритиковали КПРФ за эксплуатацию экоповестки Сопредседатель российской экологической партии «Зеленые» Александра Кудзагова укорила КПРФ за использование экологической повестки для набора политич …
20:11, ноября 21, 2025 | kommersant.ru
Депутаты правящей партии Армении напали на оппозиционеров Депутаты от правящей партии «Гражданский договор» набросились на депутатов от оппозиции на внеочередном заседании парламента. …
15:11, июля 8, 2025 | eadaily.com
Кандидата от маоистской партии не допустили к выборам в Челябинске В Челябинске один из кандидатов от Российской маоистской партии попыталась зарегистрироваться самовыдвиженцем для участия в выборах в Городскую Думу, …
15:11, августа 13, 2024 | pravda.ru
Shaman сообщил о создании партии «Мы» в подарок Мизулиной Она в любом случае не будет зарегистрирована до ближайших выборов и скорее похожа на промо пары, говорят эксперты …
00:11, сентября 2, 2025 | vedomosti.ru
Зампред партии «Яблоко» Сергей Иваненко умер в 65 лет Заместитель председателя партии «Яблоко» и глава московского отделения партии Сергей Иваненко умер на 66-м году жизни. О его смерти сообщила пресс-сл …
15:11, сентября 5, 2024 | kommersant.ru
Журналист в опале: четыре партии требуют справедливости для URA.RU Ситуация вокруг редактора свердловской редакции URA.RU Дениса Аллаярова продолжает привлекать внимание общественности и политических сил. КПРФ стала …
05:11, июня 17, 2025 | pravda.ru
Поляки в Чикаго боятся съезда Демократической партии Хотя спецслужбы США уверяют, что съезд Демократической партии в Чикаго 19—22 августа пройдёт безопасно, не все придерживаются такого же мнения. Поляк …
15:11, августа 16, 2024 | eadaily.com
В правящей партии Грузии отреагировали на очередные санкции США Лидер парламентского большинства Грузии Мамука Мдинарадзе призвал Госдепартамент США огласить имена людей, в отношении которых Вашингтон намерен ввес …
15:11, сентября 17, 2024 | gazeta.ru
Bild: на месте съезда партии АдГ разлили кислоту Двое неизвестных в масках вошли в городской культурный центр в Хенштедт-Ульцбурге (федеральная земля Шлезвиг-Гольштейн) на севере ФРГ, где планируетс …
00:11, ноября 3, 2024 | news.rambler.ru
Партии соревнуются в организации необычных акций ко Дню Победы Они занялись газификацией монументов Вечного огня, генерацией видеообразов участников ВОВ и оркестрами под окнами ветеранов …
00:11, мая 6, 2025 | vedomosti.ru
Рейтинг пророссийской партии Сары Вагенкнехт достиг рекордных 10% Рейтинг партии «Союз Сары Вагенкнехт — за разум и справедливость», руководство которой выступает против военной поддержки Украины, а также санкций в …
00:11, июля 29, 2024 | eadaily.com
Краткий курс истории Партии любителей пива // Досье Партия любителей пива (ПЛП) была основана в декабре 1993 года политтехнологом Константином Калачевым (генеральный секретарь) и юристом Дмитрием Шеста …
00:11, октября 8, 2024 | kommersant.ru
На Камчатке опустошают хранилище с санкционным СПГ: партии идут в Китай Начавшиеся поставки санкционного российского СПГ в Китай продолжаются. Грузы идут не только с проекта «Арктик СПГ — 2», но и хранилища на Камчатке, г …
15:11, сентября 23, 2025 | eadaily.com
«Единая Россия» приостановила членство в партии сенатора Савельева Тульское региональное отделение «Единой России» приостановило членство в партии и президиуме областного политосовета сенатора Дмитрия Савельева в свя …
15:11, августа 3, 2024 | eadaily.com
Россельхознадзор выявил опасное насекомое в партии салата в Забайкалье В Забайкальском крае сотрудники Россельхознадзора выявили карантинный объект — трипс Пальми — в партии салата-латука из Китая. Факт заражения салата …
15:11, октября 18, 2024 | pravda.ru
Камала Харрис стала кандидатом в президенты США от Демократической партии Демократическая партия сегодня формально определилась с кандидатом, который представит ее на предстоящих в ноябре этого года очередных президентских …
20:11, августа 6, 2024 | versia.ru
В Ярославле задержали бывшего соучредителя партии «Гражданская платформа» В Ярославле задержан депутат областной думы Михаил Писарец, сообщает Yarnews со ссылкой на собственные источники. По данным портала, это произошло во …
10:11, июня 12, 2025 | kommersant.ru
Экс-руководителя аппарата Партии пенсионеров арестовали по делу о мошенничестве Басманный районный суд Москвы арестовал до 13 декабря бывшего руководителя центрального аппарата Партии пенсионеров Михаила Фальченко, политика Олега …
00:11, октября 17, 2025 | kommersant.ru
Трамп официально выдвинут кандидатом в президенты США от Республиканской партии Дональд Трамп официально выдвинут кандидатом в президенты США от Республиканской партии, пишет Bloomberg.Делегаты на съезде Республиканской партии СШ …
10:11, июля 18, 2024 | finam.ru
Камала Харрис утверждена кандидатом в президенты США от Демократической партии Вице-президент США Камала Харрис официально приняла выдвижение в качестве кандидата в президенты США от Демократической партии на национальном съезде …
10:11, августа 21, 2024 | finam.ru
Дань защитнику Отечества // Как парламентские партии отметят 23 февраля В год 80-летия Победы в Великой Отечественной войне парламентские партии готовятся встречать День защитника Отечества в полной боевой готовности: мит …
15:11, февраля 22, 2025 | kommersant.ru
В Республиканской партии США пообещали покарать гонителей православия на Украине 20 января 2025 года, в день инаугурации Дональда Трампа, лидер молодежного крыла Республиканской партии США Кэтрин Уайтфорд пообещала, что всех гонит …
15:11, января 21, 2025 | eadaily.com
В члена партии Саакашвили кинули яйцо в прямом эфире Неизвестный бросил яйцо в члена основанной экс-президентом Михаилом Саакашвили партии «Единое национальное движение» Левана Хабеишвили в прямом эфире …
05:11, июля 19, 2025 | eadaily.com
Новые партии зерна везут в Армению через Азербайджан Новые партии зерновых в ближайшее время поступят в Армению транзитом через территорию Азербайджана и Грузии, сообщил журналистам министр экономики Ар …
15:11, декабря 15, 2025 | eadaily.com
Участников молодежного проекта ЕР привлекут к написанию программы партии Для участия в проекте «Единой России» (ЕР) по политической подготовке молодежи «ПолитЗавод» подано 15 395 заявок, регистрация завершена, сообщила пре …
10:11, мая 16, 2025 | kommersant.ru
ЦИК Молдавии не разрешил оппозиционной партии "Шанс" участвовать в выборах Центризбирком Молдавии отозвала у оппозиционной молдавской партии "Шанс" допуск к президентским выборам и референдуму об интеграции государства в ЕС. …
20:11, сентября 14, 2024 | gazeta.ru
Две оппозиционные партии подтвердили участие в парламентских выборах в Азербайджане Как минимум две политические силы, представляющие азербайджанскую оппозицию, партии «Мусават» и «Республиканская альтернатива» (ReAl) объявили, что с …
15:11, июля 9, 2024 | eadaily.com
«ВкусВилл» остановил продажу партии пельменей из-за случаев отравления «ВкусВилл» заблокировал партию и приостановил новые поставки пельменей «Мясное ассорти» от производителя «Чали» из Орловской области после сообщений …
15:11, декабря 31, 2024 | kommersant.ru
Председателем Партии пенсионеров станет врач Эрик Праздников Новым председателем центрального совета Партии пенсионеров на съезде 17 мая будет избран исполнительный вице-президент общественной организации «Обще …
20:11, мая 17, 2025 | kommersant.ru
Путин заявил о нападениях «партии войны» на «партию мира» «Партия войны» все время нападает на «партию мира». Об этом на итоговой пресс-конференции в Китае заявил президент России Владимир Путин, комментируя …
20:11, сентября 3, 2025 | news.rambler.ru
В аэропорту Кишинева задержали лидера оппозиционной партии "Шанс" В аэропорту Кишинева задержали лидера молдавской оппозиционной партии "Шанс" Алексея Лунгу после его возвращения из Москвы. Об этом сообщает Sputnik …
15:00, июня 12, 2024 | gazeta.ru
В Грузии задержали 37 человек, хранивших крупные партии оружия МВД Грузии сообщило о задержании за последние три дня 37 человек по обвинению в незаконном приобретении, хранении и ношении в особо крупном размере о …
20:11, августа 19, 2025 | eadaily.com
Под единым флагом // Чем партии отметились в день российского триколора Парламентские партии 22 августа вместе со всей страной отметили День Государственного флага Российской Федерации. «Единая Россия» (ЕР) и «Справедлива …
00:11, августа 23, 2025 | kommersant.ru
Виды на юбилей // Как парламентские партии отметят 80-летие Победы Все парламентские партии обещают сделать празднование 80-летнего юбилея Победы одним из главных событий 2025 года. Среди мероприятий, запланированных …
05:11, мая 5, 2025 | kommersant.ru
В Москве задержали сотрудника штаба кандидата партии "Яблоко" В Москве задержали политтехнолога Виталия Шушкевича, участника предвыборной кампании кандидата от "Яблока" Максима Круглова. Об этом сообщает пресс-с …
15:11, июля 6, 2024 | gazeta.ru
Недалеко от съезда Республиканской партии полицейский застрелил человека В Милуоки (штат Висконсин) примерно в полутора километрах от зоны безопасности вокруг места проведения Национального съезда Республиканской партии по …
00:11, июля 17, 2024 | gazeta.ru
Канцлер Австрии признал поражение своей партии на выборах Канцлер Австрии Карл Нехаммер признал, что Австрийская народная партия проиграла на выборах в парламент. Его слова приводит ТАСС. "К сожалению, нам н …
00:11, сентября 30, 2024 | gazeta.ru
Решение Макрона о досрочных выборах вызвало протест в его партии Соратники президента Франции Эммануэля Макрона по партии "Ренессанс" недовольны его решением об объявлении досрочных выборов. Об этом пишет Bloomberg …
08:00, июня 12, 2024 | gazeta.ru
Шольц призвал не спешить с запретом признанной экстремистской партии АдГ Исполняющий обязанности канцлера Германии Олаф Шольц призвал не спешить с процедурой запрета партии «Альтернатива для Германии» (АдГ), которую контрр …
20:11, мая 2, 2025 | eadaily.com
«Нестле Россия» частично отозвала партии детского питания «Нестле Россия» добровольно частично отозвала партии детского питания из-за усиления контроля качества сырья со стороны внешнего поставщика. Речь иде …
05:11, января 7, 2026 | forbes.ru
В Тунисе арестовали главу оппозиционной исламистской партии "Ан-Нахда" В Тунисе полицейские арестовали в населенном пункте Бордж эль-Амри неподалеку от столицы генерального секретаря оппозиционной исламистской партии "Ан …
05:11, июля 14, 2024 | gazeta.ru
Из социалистов в суверанисты: Додон объявил об изменени курса партии Председатель Партии социалистов Молдавии (ПСРМ) Игорь Додон заявил сегодня, 29 апреля, что в будущем она может стать «Партией суверенистов Республики …
20:11, апреля 29, 2025 | eadaily.com
Претендента в президенты Польши Гжегожа Брауна исключили из партии Депутата Европарламента Гжегожа Брауна, объявившего о своём желании баллотироваться в президенты Польши, исключили из партийной коалиции «Конфедераци …
15:11, января 18, 2025 | eadaily.com
Депутаты снова предложили снизить возраст для вступления в партии В Госдуме предложили снизить возрастной порог вступления в политические партии с 18 до 16 лет. Соответствующий законопроект внесла группа депутатов в …
15:11, августа 12, 2025 | kommersant.ru
В Армении освобождены сын депутата Манукяна и представители партии «Дашнакцутюн» В Армении выпустили из заключения сына депутата парламента от оппозиционной фракции «Армения» Гегама Манукяна Тарона Манукяна и еще троих представите …
20:11, июля 13, 2025 | eadaily.com
Депутат из партии Зеленского "Слуга народа" бежал с Украины Депутат Верховной рады Андрей Одарченко, который обвиняется в попытке подкупа бывшего председателя Госагентства восстановления и развития инфраструкт …
20:11, сентября 18, 2024 | gazeta.ru
Глава партии Марин Ле Пен выступает за предоставление Киеву боеприпасов При этом он высказывает свое мнение против передачи Киеву вооружений, которые могут еще больше разжечь существующий конфликт, а также не поддерживает …
20:11, июня 20, 2024 | versia.ru
Украинские силовики ворвались с обысками в офис партии Тимошенко Руководителя одной из депутатских фракций Верховной Рады Украины подозревают в подкупе народных депутатов и покупке из голосов «за» или «против» в ко …
05:11, января 14, 2026 | news.rambler.ru
ЛДПР объявила об исключении из партии депутата Ярослава Нилова Президиум Высшего совета ЛДПР объявил об исключении из партии одного из старейших депутатов — Ярослава Нилова, который был в рядах либерал-демократов …
20:11, июня 25, 2025 | forbes.ru
Bloomberg: Решение Макрона о роспуске парламента вызвало хаос в его партии Решение президента Франции Эммануэля Макрона распустить Национальное собрание и провести перевыборы вызвало недовольство и хаос среди его окружения, …
10:16, июня 12, 2024 | eadaily.com
Орбана избрали кандидатом на пост премьера Венгрии от правящей партии Правящая партия "ФИДЕС - Венгерский гражданский союз" избрала премьер-министра Венгрии Виктора Орбана в качестве кандидата от фракции на пост главы п …
20:11, января 10, 2026 | gazeta.ru
Оппозиционные партии предложили президенту Абхазии «очистить ряды госаппарата» Несколько абхазских оппозиционных партий, а также политических объединений обратились с публичным предложением к президенту республики Бадре Гунба с …
15:11, октября 29, 2025 | eadaily.com
В Будапеште нашли лицемерными действия председателя Европейской народной партии Действия Манфреда Вебера, председателя Европейской народной партии в Европейском парламенте, являются ничем иным, как очередным «лицемерным нападение …
15:11, июля 31, 2024 | eadaily.com
В Госдуме объяснили успех партии Бабиша на парламентских выборах в Чехии Экс-премьер Чехии Андрей Бабиш и его оппозиционная партия ANO («Акция недовольных граждан») смогли победить на парламентских выборах в республике в п …
20:11, октября 6, 2025 | news.rambler.ru
Министры из партии уволенного Шольцем главы Минфина ФРГ подали в отставку Свободная демократическая партия (СвДП), входящая в правящую коалицию в Германии, объявила о выводе своих министров из состава правительства после то …
05:11, ноября 7, 2024 | eadaily.com
Бывший глава Минобороны КНР исключён из Коммунистической партии по подозрению в коррупции Проверка в отношении бывшего министра обороны КНР выявила систематические нарушения, включая злоупотребления служебным положением и коррупцию …
20:11, июня 27, 2024 | topwar.ru
Отдача: в Дрездене обстреляли штаб-квартиру партии канцлера Шольца В немецком Дрездене в Саксонии неизвестные обстреляли штаб-квартиру партии канцлера Германии Олафа Шольца — СДПГ. Об этом сообщает телеграм-канал «Bi …
00:11, июля 5, 2024 | eadaily.com
В офисах старейшей армянской партии идут обыски — член АРФД В офисах партии «Дашнакцутюн» (АРФД) в Вайке и Ехегнадзоре (Вайоцдзорская область Армении) проходят обыски и задержания представителей этого политобъ …
20:11, июня 14, 2024 | eadaily.com
Президентом партии избран политик, продвигающий лозунг «Польша для поляков!» Польский политик Кшиштоф Босак единогласно избран президентом партии «Национальное движение», входящей в «Конфедерацию». В своей речи он заявил о нео …
10:11, июня 15, 2025 | eadaily.com
В партии Марин Ле Пен выступили против передачи Украине дальнобойного оружия Один из лидеров французской партии «Национальное объединение» назвал личной «красной линией» передачу Киеву дальнобойного вооружения …
20:11, июня 19, 2024 | topwar.ru
Единство на любой вкус // Парламентские партии отметят ноябрьские праздники Учрежденный 20 лет назад День народного единства парламентские партии отметят по-разному. Для «Единой России», «Справедливой России» и ЛДПР этот праз …
10:11, ноября 3, 2025 | kommersant.ru
США встраивают скрытые трекеры в партии чипов для борьбы с поставками в Китай Американские власти начали помещать устройства слежения в партии микросхем, которые, по их данным, могут быть незаконно переправлены в Китай. Об этом …
05:11, августа 14, 2025 | ixbt.com
Ростех поставил армии новые партии "Краснополя-М2" и ракет для "Корнета" Холдинг "Высокоточные комплексы" госкорпорации "Ростех" передал Министерству обороны России очередные партии управляемых артиллерийских снарядов "Кра …
05:11, ноября 8, 2025 | военное.рф
Экс-замглавы МВД Британии включился в борьбу за пост лидера оппозиционной партии Бывший замглавы МВД Великобритании Роберт Дженрик включился в борьбу за пост лидера оппозиционной Консервативной партии. Об этом сообщает ТАСС. Он по …
10:11, июля 26, 2024 | gazeta.ru
Умер бывший лидер французской партии «Национальный фронт» Жан-Мари Ле Пен Умер бывший лидер французской партии «Национальный фронт» Жан-Мари Ле Пен. Ему было 96 лет. По словам членов его семьи, политик умер «в окружении сво …
00:11, января 8, 2025 | forbes.ru
Раскрыта причина переноса Илоном Маском создания своей партии Американский бизнесмен Илон Маск принял решение приостановить реализацию проекта по созданию собственной политической партии. Основной причиной таког …
05:11, августа 21, 2025 | versia.ru
Горис завышенных ожиданий: в партии Пашиняна уверены в «однозначной победе» Спустя два дня после встречи с президентом Ильхамом Алиевым в Абу-Даби премьер-министр Никол Пашинян собрал в армянском Горисе (Сюникская область) ак …
20:11, июля 13, 2025 | eadaily.com
«Превентивный импичмент»: последний «ход конём» в покерной партии Сержа Саргсяна? Внутриполитическая ситуация в Армении с начала 2025 года входит в новую зону турбулентности. Раскол между двумя основными оппозиционными силами обрет …
15:11, апреля 29, 2025 | eadaily.com
Абхазские партии и Общественная палата призвали перейти к смешанным выборам Члены Общественной палаты Абхазии, руководители политических партий и общественных организаций подписали совместное заявление о переходе к смешанной, …
00:11, сентября 13, 2025 | eadaily.com
Думские партии выдвинули разное количество ветеранов на выборах в заксобрания У «Единой России» участники спецоперации идут в составе общерегиональных троек в нескольких субъектах РФ …
00:11, июля 15, 2024 | vedomosti.ru
«Что задумал Гагик?»: про «Правильную Армению», отказ от партии и месседж Царукяна Вчера многолетний председатель партии «Процветающая Армения» (ППА) Гагик Царукян опубликовал статью, которая, по сути, является концептуальной и полн …
15:11, марта 4, 2025 | eadaily.com
Politico: ЕС может ввести санкции против правящей партии Грузии Евросоюз может прибегнуть к введению санкций против партии «Грузинская мечта» на фоне протестов в Грузии и действий её властей, направленных на прекр …
05:11, декабря 3, 2024 | versia.ru
В старейшей армянской партии сравнили действия властей с «методами большевиков» По результатам обысков в офисах партии «Дашнакцутюн» (АРФД) в Вайоцдзорской области Армении арестованы пять представителей политобъединения, ещё трое …
00:11, июня 19, 2024 | eadaily.com
Протестующие в Тбилиси напали на штаб правящей партии «Грузинская мечта» Митингующие в Тбилиси разбили окна офиса правящей партии «Грузинская мечта» на проспекте Руставели и забросали его камнями и яйцами, передает корресп …
20:11, ноября 30, 2024 | eadaily.com
Суд Молдавии ограничил деятельность Партии регионов — её лидер бьет укронацистов Бельцкий суд постановил ограничить деятельность Партии регионов Молдавии сроком на три месяца. Инициатором выступило Министерство юстиции РМ, которое …
10:11, сентября 12, 2024 | eadaily.com
Зампреду партии «Яблоко» Максиму Круглову продлили меру пресечения Замоскворецкий районный суд Москвы продлил на месяц арест заместителя председателя партии «Яблоко» Максима Круглова, обвиняемого в фейках об армии. О …
00:11, ноября 27, 2025 | kommersant.ru
В правящей партии Грузии заявили, что не считают Россию своим другом Председатель комитета по внешним связям парламента Грузии Николоз Самхарадзе в интервью сделал неожиданное заявление на тему отношений страны с Росси …
00:11, апреля 2, 2025 | versia.ru
ЦИК Молдавии разрешил партии «Возрождение» из блока Шора агитировать против ЕС Центральная избирательная комиссия Молдавии зарегистрировала сегодня, 6 сентября, партию «Возрождение» как участника конституционного референдума о в …
20:11, сентября 6, 2024 | eadaily.com
Роман Путин стал главой партии «Народ против коррупции» Двоюродный племянник президента России и владелец компании «Звезда Ойл» намерен идти в Госдуму. Роман Путин стал лидером партии «Народ против коррупц …
00:11, декабря 1, 2024 | versiya.info
Власти Грузии собираются избавиться от партии Саакашвили как немцы от нацистов Премьер Грузии Ираклий Кобахидзе сравнил планы запрета основных оппозиционных партий страны «избавлением немецкой политики от партии Гитлера после 19 …
05:11, сентября 6, 2024 | eadaily.com
"Ростех" поставил армии новые партии "Краснополя-М2" и ракет для "Корнета" Холдинг "Высокоточные комплексы" ("Ростех") передал Минобороны России очередные партии управляемых артиллерийских снарядов "Краснополь-М2" и ракет дл …
10:11, ноября 10, 2025 | военное.рф
Активисты ЛДПР покинули молодежную организацию партии в Тюменской области Помощник координатора тюменского регионального отделения ЛДПР по работе с молодежью и депутат думы Московского сельского поселения Тимур Темуркаев за …
05:11, февраля 7, 2025 | kommersant.ru
В Финляндии озвучили сроки поставки первой партии дронов на Украину Финская оборонная компания Summa Defence подтвердила планы по поставке первой партии беспилотных летательных аппаратов Украине во второй половине тек …
10:11, августа 24, 2025 | versia.ru
Полиция Молдавии начала уголовное преследование лидера партии «Шанс» Полиция Молдавии сегодня, 4 июля, сообщила, что в отношении лидера оппозиционной партии «Шанс» Алексея Лунгу возбуждено уголовное дело. Задержанного …
15:11, июля 5, 2024 | eadaily.com
Der Spiegel: канцлером Австрии впервые в истории станет представитель ультраправой партии FPÖ Он выступает против поставок оружия Киева и настаивает на необходимости отмены антироссийских санкций …
20:11, января 6, 2025 | topwar.ru
МИД Чехии: первые партии боеприпасов в рамках чешской инициативы уже прибывают на Украину Всего в рамках инициативы чешского правительства Прага уже поставила ВСУ более миллиона артиллерийских боеприпасов …
15:11, июня 15, 2024 | topwar.ru
Опять будет пять // С какими рейтингами партии входят в думскую кампанию Аналитический центр ВЦИОМ опубликовал результаты последнего в 2025 году еженедельного опроса, посвященного политическим предпочтениям россиян. Исслед …
05:11, января 18, 2026 | kommersant.ru
Украинские власти решили через евангелистов получить поддержку Республиканской партии США Киев для лоббирования своих интересов решил с помощью евангелистов получить поддержку Республиканской партии США. Об этом сообщает газета Washington …
05:11, сентября 11, 2024 | gazeta.ru
Масштабная "зачистка" в КПРФ Приморья: из партии исключили депутатов и местных лидеров Продливший свои полномочия на посту первого секретаря Крайкома Анатолий Долгачев избавился от внутренней оппозиции …
15:11, декабря 19, 2024 | primamedia.ru
День специального единства // Российские партии отметят ноябрьские праздники с прицелом на СВО Большинство парламентских партий отметят День народного единства с акцентом на специальной военной операции (СВО). Например, «Единая Россия» проведет …
20:11, ноября 2, 2024 | kommersant.ru
В партии Пашиняна не понимают тактику оппозиции: «Ваши действия очень странные» Рубен Рубинян, заместитель председателя Национального собрания (НС) Армении, не понимает логики действий оппозиции, передаёт сегодня, 11 июня, «Армен …
11:16, июня 11, 2024 | eadaily.com
Новогодние построения // Парламентские партии отметят праздник мероприятиями в поддержку спецоперации В новогодние праздники депутаты Госдумы от большинства парламентских партий, завершившие на прошлой неделе осеннюю сессию, продолжат свою работу, сде …
20:11, декабря 26, 2024 | kommersant.ru
Партийцы выступили по максимуму // На региональные выборы-2024 пришли все российские партии 23 политические партии воспользовались правом выдвижения кандидатов на сентябрьские выборы в регионах. Де-факто это все действующие в России избирате …
05:11, июля 30, 2024 | kommersant.ru
Любовь к отеческим словам // Партии отпраздновали День отца с разными акцентами День отца, отмечавшийся в России 19 октября в пятый раз, уже вошел в «обязательную программу» парламентских партий, но с разными акцентами. Если «Еди …
05:11, октября 20, 2025 | kommersant.ru
Минтранс рассказал об отправке первой партии зерна в Армению через Азербайджан Российские железные дороги (РЖД) организовали отправку более одной тысячи тонн пшеницы со станции Димитровград в Ульяновской области в Армению через …
05:11, ноября 6, 2025 | news.rambler.ru
Партии полезли в заначки // В третьем квартале они израсходовали втрое больше, чем получили В третьем квартале 2024 года российские партии заработали почти 1,7 млрд руб.— на треть больше, чем годом ранее, следует из опубликованных Центризбир …
10:11, декабря 3, 2024 | kommersant.ru
Партийно-гуманитарная система // Как парламентские партии помогают жителям Курской области К поддержке жителей, пострадавших от боевых действий в Курской области, подключились все парламентские партии. Как выяснил “Ъ”, общей задачей для них …
05:11, августа 14, 2024 | kommersant.ru
Материнская плата // Парламентские партии заготовили ко Дню матери подарки, законопроекты и амнистию День матери, который в России в этом году выпадает на 30 ноября, уже стал поводом для повышенной партийной активности. В фокус внимания политиков поп …
00:11, ноября 27, 2025 | kommersant.ru
Yonhap: Лидер правящей партии Южной Кореи призвал к импичменту президента Лидер правящей южнокорейской партии «Гражданская сила» Хан Дон Хун призвал к скорейшему отстранению президента страны Юн Сок Ёля от должности, переда …
05:11, декабря 6, 2024 | eadaily.com
После обретения независимости на Украине, по сути, было только две партии — Азаров После обретения независимости на Украине, по сути, существовали всего две политические партии, хотя их насчитывалось более 300, — партия разрушения и …
05:11, февраля 12, 2025 | eadaily.com
«У Чили сильный паспорт»: депутата-единоросса выгнали из партии из-за хвастливой жены Неожиданно быстро закончился скандал с депутатом «Единой России» из гордумы Тольятти, председателем комиссии по городскому хозяйству Александром Доро …
05:11, декабря 17, 2025 | eadaily.com
Некруглое видится на расстоянии // Как парламентские партии отметят 11-ю годовщину крымского референдума Одним из главных событий предстоящей региональной недели, которую депутаты Госдумы проведут в своих округах, станет празднование очередной годовщины …
05:11, марта 10, 2025 | kommersant.ru
В Токио мужчина напал на штаб правящей партии Японии и канцелярию премьера Мужчина бросил несколько бутылок с зажигательной смесью в штаб правящей партии Японии и пытался протаранить машиной канцелярию премьера. Об этом 19 о …
15:11, октября 20, 2024 | eadaily.com
Наблюдатель с гранатой // Партии договорились с общественниками о совместном контроле за осенними выборами Представители 17 партий подписали в Общественной палате РФ традиционное соглашение о координации наблюдения на осенних выборах. Участники кампании пр …
15:11, августа 13, 2024 | kommersant.ru
Молодёжное крыло Республиканской партии США назвало неприемлемым притеснение православия на Украине Сопредседатель республиканского «комсомола» обратила внимание на отсутствие на Украине религиозных свобод и предрекла киевскому режиму незавидную уча …
00:11, июня 10, 2025 | topwar.ru
Бунт на корабле: Депутат от партии Зеленского публично потребовал отставки Ермака Глава офиса президента Украины Андрей Ермак должен уйти в отставку. Об этом заявил в эфире «Радио Свобода»*** депутат Верховной рады от партии «Слуга …
00:11, ноября 19, 2025 | eadaily.com
Вучич: Протестующие разрушили офис правящей партии Сербии в Нови-Саде Протестующие разрушили офис правящей Сербской прогрессивной партии (СПП) в городе Нови-Сад, заявил президент республики Александр Вучич в эфире Infor …
15:11, августа 15, 2025 | eadaily.com
Лавров высказался о "точке невозврата" в одном желании "партии войны" в Европе Россия видит, что "партия войны" в Европе в своих антироссийских идеях готова идти до конца. Об этом заявил глава МИД РФ Сергей Лавров в интервью ТАС …
10:11, декабря 28, 2025 | gazeta.ru
Партии ждут перемен // Эксперты и политики прогнозируют разморозку политической дискуссии К единому дню голосования 2025 года, который станет прологом выборов в Госдуму-2026, в российской политике вновь обретут значимость смыслы, идеология …
10:11, февраля 26, 2025 | kommersant.ru
Стало известно об отправке на Украину партии британских ракет Storm Shadow Великобритания недавно передала Украине дополнительную партию ракет Storm Shadow. Об этом пишет Bloomberg со ссылкой на источники, знакомые с ситуаци …
15:11, ноября 3, 2025 | news.rambler.ru
Трамп переписал подготовленную для съезда республиканской партии речь после покушения Кандидат на пост президента США Дональд Трамп полностью переписал свою речь, с которой намерен выступить в ближайшие дни на съезде Республиканской па …
10:11, июля 15, 2024 | versia.ru
Глава правящей партии Грузии Ираклий Гарибашвили объявил об уходе из политики Занимавший ранее должность премьера Грузии Ираклий Гарибашвили решил пресечь все появившиеся спекуляции и рассказал о будущей политической деятельнос …
20:11, апреля 25, 2025 | versia.ru
Лидер партии «Альтернатива для Германии» призвала Олафа Шольца «собирать чемоданы» Алиса Вайдель, которая занимает пост сопредседателя правой партии «Альтернатива для Германии» (АдГ), выступила с призывом провести в стране федеральн …
10:11, сентября 3, 2024 | versia.ru
Удар по оппозиции: в Молдавии перед выборами запретят все партии блока «Победа» В Молдавии хотят запретить деятельность политических формирований, которые являются преемниками партий, объявленных ранее неконституционными. Соответ …
20:11, марта 21, 2025 | eadaily.com
Куда ж им плыть // Парламентские партии отчитались о своих планах на региональные и федеральные выборы Экспертный институт социальных исследований (ЭИСИ) провел в четверг круглый стол «Месяц до выборов: партийная активность и конкуренция». Своими мысля …
05:11, августа 9, 2024 | kommersant.ru
Мосийчук* назвал депутатов партии «Слуга Народа» агентами Кремля и Слугами Сатаны Украинскую партию «Слуга Народа», которая была создана главой киевского режима Владимиром Зеленским, следует переименовать в партию «Слуги Сатаны». …
15:11, апреля 17, 2025 | eadaily.com
Глава МИД Литвы Ландсбергис отказался от мандата после поражения партии на выборах в парламент На состоявшихся в Литве парламентских выборах победу одержали оппозиционные социал-демократы, а партия «Союз Отечества - Литовские христианские демок …
05:11, октября 29, 2024 | versia.ru
Председатель Госдумы Володин заявил, что СССР распался из-за партии, утратившей связь с народом Разрушение Советского Союза произошло из-за того, что правящая партия, обладающая полным контролем над властью, оказалась отчужденной от интересов на …
20:11, октября 30, 2024 | mockva.ru
Партийно-подследственная группа // Бывшего функционера Партии пенсионеров арестовали за мошенничество на выборах Суд в Москве по ходатайствам ГСУ СКР арестовал бывшего руководителя центрального аппарата Партии пенсионеров, президента ассоциации «Анкор» (Мытищи) …
00:11, октября 17, 2025 | kommersant.ru
Обучающий момент // Парламентские партии приступили к отбору кандидатов на ближайшие и последующие выборы Высшая партийная школа «Единой России» открыла курс «Политический лидер» для участников кадрового проекта «Политстарт», которые смогут претендовать н …
20:11, апреля 9, 2025 | kommersant.ru
Коммунисты поставили себя в пример // В КПРФ придумали, как повысить боеспособность партии и страны КПРФ на пресс-конференции 23 июня представила политический отчет пленума ЦК, посвященный тому, как выстоять в условиях «беспощадной войны на уничтоже …
00:12, июня 25, 2025 | kommersant.ru
Europe 1: Макрон может подать в отставку на фоне провала его партии на выборах в Европарламент Неудача на выборах в Европарламент и грядущие парламентские выборы во Франции могут вынудить Макрона уйти в отставку, отмечает радиостанция Europe 1 …
13:32, июня 11, 2024 | topwar.ru
Глава оппозиционной партии Уганды Боби Вайн в момент покушения был ранен в ногу Глава оппозиционной партии Уганды «Платформа национального единства» Роберт Киагуланьи Ссентаму (Боби Вайн) получил ранение в ногу в результате покуш …
05:11, сентября 4, 2024 | news.rambler.ru
Сенсация в Румынии: действующий премьер вылетел из гонки и оставил пост лидера партии Первый тур президентских выборов в Румынии завершился сенсацией. Согласно частичным результатам, основанным на совокупном результате подсчета 99,9% п …
20:11, ноября 25, 2024 | eadaily.com
Турция и Сирия могут провести масштабную операцию против Рабочей партии Курдистана Турция и Сирия могут провести масштабную военную операцию против курдских боевиков Рабочей партии Курдистана (РПК) в случае, если Запад выдвинет "нов …
05:11, января 9, 2025 | versia.ru
Первые партии ракет для Patriot и NASAMS Киев начнет получать в ближайшие недели Первые партии ракет для систем противовоздушной обороны Patriot и NASAMS поступят на Украину из США в течение ближайших недель. Об этом заявил коорди …
00:11, июня 21, 2024 | eadaily.com
Новым премьер-министром Франции стал лидер центристской партии - союзник Макрона Во Франции после летних парламентских выборов, когда партия президента Эммануэля Макрона не сумела сохранить большинство в парламенте, продолжается п …
20:11, декабря 13, 2024 | topwar.ru